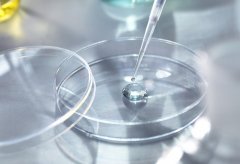
浙江试管攻略，找医院、查费用、看成功率...

助孕资讯

-
 韶关市试管私人机构名单已公布!
韶关市试管私人机构名单已公布!韶关已有私人机构提供三代试管技术服务。这种技术被广泛应用于不孕不育治疗,为那些无法自然受孕的夫妇带来了生育的希望。下面将介绍韶关三代试管私人机构以及相关内容。 韶关三代试
作者:木易 136 发布时间:2026-04-14 -
 贵州三代试管哪家医院可以做?费用怎么样?
贵州三代试管哪家医院可以做?费用怎么样?贵州试管技术为不孕不育夫妇提供了一条可行的解决途径。不孕不育问题是许多夫妇面临的困扰,而传统的治疗方法并不能奏效。通过试管技术,医生可以从女性身体中提取卵子并与
作者:木易 89 发布时间:2026-04-14 -
 陕西省人民医院试管成功率如何?
陕西省人民医院试管成功率如何?试管技术是一种辅助生殖技术,通过体外受精将受精卵移植到母体子宫内,帮助那些无法自然怀孕的夫妇实现生育梦想。对于许多不孕不育夫妇来说,试管技术提供了一个重要的机会
作者:木易 119 发布时间:2026-04-14 -
 西安医院供卵三代试管导航,让你助孕不迷路!
西安医院供卵三代试管导航,让你助孕不迷路!对于不孕不育患者来说,除了常规治疗外,只有通过辅助生殖技术才能成功实现生孩子的愿望。由于中国公立医院的卵子供应需要等待,所以患者将希望寄托在西安供卵试管正规机构。 西安供
作者:木易 151 发布时间:2026-04-14 -
 绝经非终点!55岁女性试管备孕指南:操作流程详解与五大关键注意事项
绝经非终点!55岁女性试管备孕指南:操作流程详解与五大关键注意事项对于大部分女性来说,年龄在50岁左右一般会面临绝经问题,对于绝经了的妇女来说,如果想要做试管,需要先将卵巢功能恢复后才可以。那么,55岁绝经了怎么做试管呢?有什么好的方法呢
作者:雨诗 109 发布时间:2026-04-14 -
 银川三代试管费用整理
银川三代试管费用整理三代试管技术是一项先进的辅助生殖技术,为不孕不育夫妇提供了实现生育梦想的机会。然而,对于许多夫妇来说,三代试管的费用是一个重要的考虑因素。在银川地区,了解三代试
作者:木易 84 发布时间:2026-04-14 -
 潍坊市三代试管机构选择小妙招
潍坊市三代试管机构选择小妙招潍坊市的三代试管包成功率相对较高,但仍需要选择可靠的医院进行操作。三代试管包是一项现代的生殖技术,可以帮助许多不孕不育夫妇实现生育愿望。在潍坊市,有几家知名的医院提供这
作者:木易 96 发布时间:2026-04-14 -
 西安最厉害三代试管助孕机构在哪?看这份排行榜和医院详情
西安最厉害三代试管助孕机构在哪?看这份排行榜和医院详情西安有几家三代试管助孕机构在行业中名列前茅。这些机构以其专业的医疗团队、先进的设备和高效的服务着称。以下将详细介绍西安排名前五的三代试管助孕机构。 西安市妇幼保健院 作为西
作者:木易 81 发布时间:2026-04-14 -
 乌克兰试管名声卓著,一文了解三家知名的三代试管医院
乌克兰试管名声卓著,一文了解三家知名的三代试管医院乌克兰在欧洲试管领域名声卓著,以下是该国三家顶尖的三代试管医院:第一家是Biotexcom,以其高成功率和先进设备闻名;第二家是BIsida Clinic,因其综合服务和国际声誉受到广泛认可;第
作者:盼盼 67 发布时间:2026-04-14 -
 三代试管费用明细及注意事项,选择成功率高的医疗机构指南
三代试管费用明细及注意事项,选择成功率高的医疗机构指南2024年做三代试管的全程费用大约在5至10万元人民币之间,具体费用因医院、地区和个体情况而有所不同。费用主要包括前期检查、促排卵、取卵、胚胎培养、基因筛查和胚胎移植等。选择
作者:盼盼 91 发布时间:2026-04-14 -
浙江试管攻略,找医院、查费用、看成功率...
浙江试管攻略,找医院、查费用、看成功率...近年来随着科技的不断进步,三代试管技术在生育医学领域中得到了广泛应用。那么在浙江地区进行三代试管需要多少费用?成功率如何呢? 浙江地区三代试管费用 在浙江地区,进行三代试管的
作者:木易 188 发布时间:2026-04-14 -
 为什么试管反复不着床?受什么因素影响?
为什么试管反复不着床?受什么因素影响?试管反复不着床的情况,首先应从患者自身原因找起。可能的原因包括女性子宫环境不佳、激素水平异常、胚胎质量不佳等。此外,生活习惯、心理状态等因素也可能对着床产生影响。因此,
作者:盼盼 140 发布时间:2026-04-14
